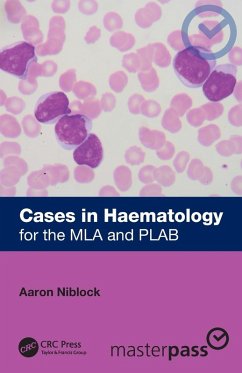

MLA Made Easy
Citation Basics for Beginners

PAYBACK Punkte
25 °P sammeln!
A concise, handy guidebook for teaching correct MLA-style citation to middle and high school researchers. MLA Made Easy: Citation Basics for Beginners offers an effective way to introduce proper research citing to those who are new to research and the MLA style.